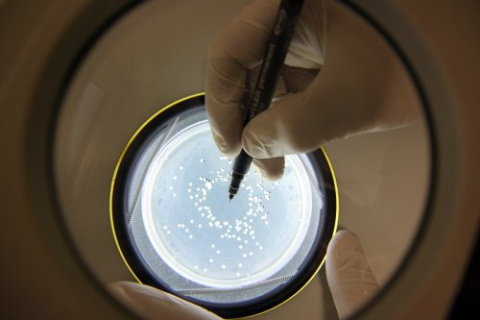

Ecología
Jane Goodall: “Estamos viviendo la sexta extinción masiva de especies, causada por nosotros”
La primatóloga Jane Goodall está de gira por España. Ayer por la mañana posó antes de la rueda de prensa en el bosque inundado de CosmoCaixa, donde por la tarde dio una conferencia en la que buena parte del auditorio eran niños y adolescentes. Como es habitual en ella, apareció con el pelo blanco recogido en una coleta, fular en los hombros y un jersey de cuello alto rodeado por un colgante con la silueta de África.
Después de su paso por Barcelona, Goodall ofrecerá otras dos charlas más hoy y mañana en Madrid, también con todas las entradas agotadas. El éxito de su agenda la asemeja más a una estrella del rock que a una científica y activista medioambiental.
“Dejadme que empiece como siempre hago”, y saludó a la audiencia en chimpancé, una llamada a la que algunos respondieron con onomatopeyas similares. Así comenzó su intervención en la que hizo un repaso de su historia de vida, con reiteradas menciones al apoyo incondicional de su madre, y propagó desde la emoción su mensaje de preservación de las especies y de los ecosistemas.
“Para mí los chimpancés tienen nombre, no son un número”, recordó de las primeras críticas que recibió por sus observaciones en la Universidad de Cambridge (Reino Unido).
Ahora, esta mensajera de la paz de la Organización de las Naciones Unidas (ONU) está a punto de celebrar seis décadas de investigaciones en las selvas tropicales africanas. A sus 84 años sigue viajando por todo el mundo más de 300 días al año para perseguir su misión de dejar un planeta mejor a las futuras generaciones, tal y como subrayaron los responsables del Instituto Jane Goodall (IJG) en España, con sede en Barcelona desde 2007, que la han traído al país.
![[Img #53808]](https://noticiasdelaciencia.com/upload/images/12_2018/6873_jane-goodall-estamos-viviendo-la-sexta-extincion-masiva-de-especies-causada-por-nosotros_image_380.jpg?23)
Jane Goodall en barcelona. (Foto: Núria Jar, SINC)
“Es un momento maravilloso para estudiar la inteligencia animal”, dijo a los jóvenes, que la escucharon con atención y sin moverse de la butaca durante una hora y veinte minutos. La primatóloga lamentó no haber podido estudiarla en su época, cuando se consideraba que no existía en otras especies.
Con la ayuda de los peluches que a menudo la acompañan en sus conferencias, puso ejemplos de las capacidades cognitivas de ratas, cerdos y vacas. Ella fue la primera en describir que los chimpancés, además de los humanos, usaban herramientas. Denunció la dificultad de continuar estudiando esta especie en estado salvaje, ya que muchos están amenazados por el tráfico ilegal, así como por la deforestación y la acidificación de los océanos que impactan en sus ecosistemas.
Fue por la mañana, en una breve atención a medios de comunicación, cuando advirtió a los periodistas: “Estamos viviendo la sexta extinción masiva de especies, causada por nosotros”. Su visita a la península es un impulso para la campaña Forever Wild (Salvaje para siempre, en inglés), que el IJG lanzó el año pasado para denunciar el tráfico ilegal de animales salvajes, no solo chimpancés, y concienciar a las futuras generaciones de este problema.
Goodall se refirió al pangolín como la especie más amenazada del planeta, perseguido por cazadores furtivos por sus escamas, que son muy valoradas por la medicina tradicional asiática.
Precisamente, la primatóloga señaló un repunte del tráfico ilegal de especies salvajes en Asia, sobre todo en China, donde los chimpancés también se han convertido en un elemento de entretenimiento, como lo fueron –y siguen siendo– en países de Europa y los Estados Unidos. El negocio mueve entre 8.000 y 20.000 millones de euros anuales en todo el mundo y es el tercero más lucrativo, solo por detrás del tráfico ilegal de drogas y armas, según un informe que presentó el pasado mes de junio el Fondo Mundial para la Naturaleza (WWF).
Esta no fue la primera vez que Goodall visitaba Barcelona, pero muchas personas hacían cola para tomar una buena posición en el auditorio. La premio Príncipe de Asturias en 2003 aprovechó la cita para hacer apología de la curiosidad.
Hacerse preguntas, cometer errores, no desistir y tener paciencia son habilidades que dijo haber aprendido con cuatro años durante unas vacaciones familiares en una granja, en su primera experiencia observando animales. Las inquietudes científicas parecían estar bien despiertas entre el público, ya que muchos niños la aplaudieron de pie e hicieron cola para conseguir un autógrafo y una foto con ella.
Aparte de apelar directamente a los más jóvenes, en su intervención no olvidó poner en valor la implicación de las comunidades locales en la sostenibilidad de los proyectos de conservación. Antes de terminar, pidió a los miembros de su equipo español que subieran al escenario y pidió voluntarios y donaciones. Su nombre es toda una marca que cuenta con treinta oficinas en todo el mundo y más de ochenta países que secundan su lucha.
No dio entrevistas: “No es que yo esté cansada, es mi voz la que lo está. Soy afortunada de tener un cuerpo fuerte y resistente”, se disculpó al finalizar. (Fuente: SINC/Núria Jar)